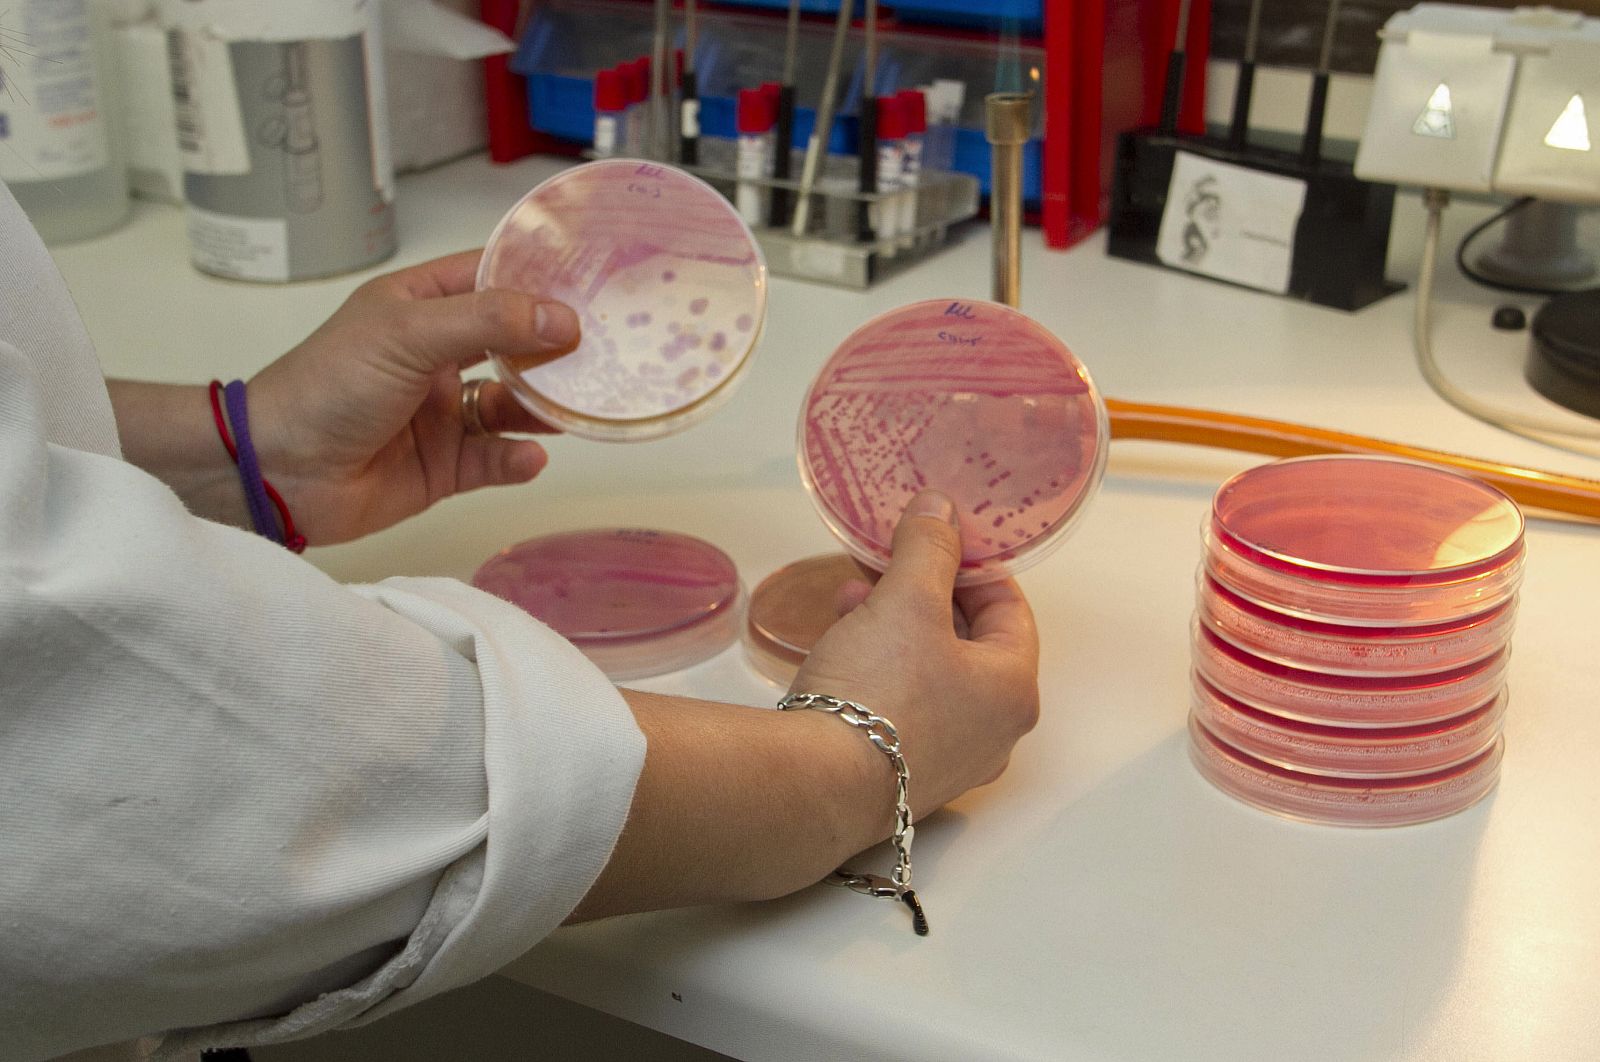
RUEDA DE PRENSA EN LUGO

La OMS confirma que la cepa mortal de la bacteria E. coli se transmite de persona a persona
- Puede transmitirse a través de las heces o por la vía oral
- Hasta ahora, todos los casos "están relacionados con el norte de Alemania"
- 19 personas han fallecido y se han registrado contagios en 13 países
- Un laboratorio italiano descarta la relación entre las verduras y el contagio
Enlaces relacionados

La Organización Mundial de la Salud (OMS) ha confirmado este viernes que la bacteria intestinal E. coli que ha causado la muerte a 19 personas puede transmitirse de persona a persona a través de las heces o por la vía oral.
"Este tipo de transmisión nos preocupa y por esta razón quisiéramos que se refuercen los mensajes relativos a la higiene personal", ha declarado la epidemióloga de la OMS, Andrea Ellis.
La especialista ha señalado que por el momento todos los casos "están relacionados con el norte de Alemania", de modo que se cree que la exposición a la extraña bacteria "está limitada a esa área".
“La OMS confirma que todos los casos están relacionados con el norte de Alemania“
Sobre las vías de transmisión, Andrea Ellis ha explicado que el contagio "puede ocurrir sin una higiene adecuada" por lo que una medida de prevención eficaz es lavarse las manos después de ir al baño y antes de tocar los alimentos.
Aunque inicialmente la alerta sanitaria se relacionó con el consumo de pepinos y otros vegetales, un laboratorio italiano ha asegurado que no hay "ninguna prueba" de que las verduras sean las causantes de la infección.
Afectados en 13 países
Hasta el momento, la bacteria E. coli ha cauado 18 muertes en Alemania y otra en Suecia.
La última víctima declarada es una mujer de 80 años que ha fallecido en una clínica del estado de Mecklemburgo-Pomerania Occidentall, en el noreste del país.
Además, ya son 13 los países donde se han registrado casos de personas afectadas, Alemania, Austria, República Checa, Dinamarca, Francia, Holanda, Noruega, España, Suecia, Suiza, Reino Unido, EE.UU. y Finlandia, que ha sido el último en unirse a la lista.
Según el Instituto Finlandés de Salud y Bienestar (THL) el pactiente afectado fue ingresado en un hospital de Helsinki a finales de mayo tras regresar de un viaje a Alemania.
El 95% de los casos declarados, 1.823, se concentran en el norte de Alemania. En todos ellos se trata de personas que residen o han visitado recientemente Alemania durante el período de incubación de la infección, excepto en uno, que se infectó tras tener contacto con alguien que había estado en Alemania.
La OMS ha resaltado a través de su Oficina Regional Europea que no recomienda ningún tipo de restricciones comerciales relacionadas con el brote y que mantiene informados a los estados miembros de la organización sobre su evolución, además de proporcionarles ayuda técnica y de investigación.
El jueves, científicos alemanes y chinos lograron descifrar el genoma de la E. coli, identificado como un cruce hasta ahora desconocido de bacterias.
Mayor impacto entre las mujeres
Durante la conferencia de prensa de la OMS, la epidemióloga Andrea Ellis ha comentado que los adultos, pese a no ser el grupo de mayor riesgo, son los que están resultando más afectados.
“Los adultos son los más afectados aunque no suponen el grupo de mayor riesgo“
Menos extraño es que el mayor impacto se esté observando entre las mujeres, debido a sus "preferencia alimenticias" ya que, según Ellis, ellas tienden a consumir más vegetales crudos en ensaladas y se cree que es allí donde está el origen de la bacteria.
"Lo más probable es que en este caso el modo de transmisión sea a través de los alimentos, pero sabemos cual. Y esto tampoco significa que no pueda ser otra cosa", ha puntualizado, tras explicar que el agua, el contacto con animales o con personas infectadas también son otros modos conocidos de transmisión.
Además, Ellis ha precisado que la cepa de la bacteria letal que circula en Alemania se había visto ya en el ser humano pero siempre de manera esporádica y nunca en situaciones de epidemia.
La experta ha reconocido que "hay algo en esta bacteria que la hace especialmente virulenta" pero aún no se ha podido descifrar lo que es.
En cuanto al tratamiento, la OMS desaconseja la administración de antidiarreicos o antibióticos "porque pueden empeorar la situación" aunque "puede haber casos particulares que los requieran".
Esto se debe a que los antidiarréicos ralentizan el tránsito intestinal, lo que hace que el riesgo de absorción de la toxina liberada por el E. coli sea mayor.
Ellis ha asegurado que "es demasiado pronto" para determinar si este brote epidémico es pasajero o hay que esperar a que la extraña bacteria circule durante mucho tiempo.



